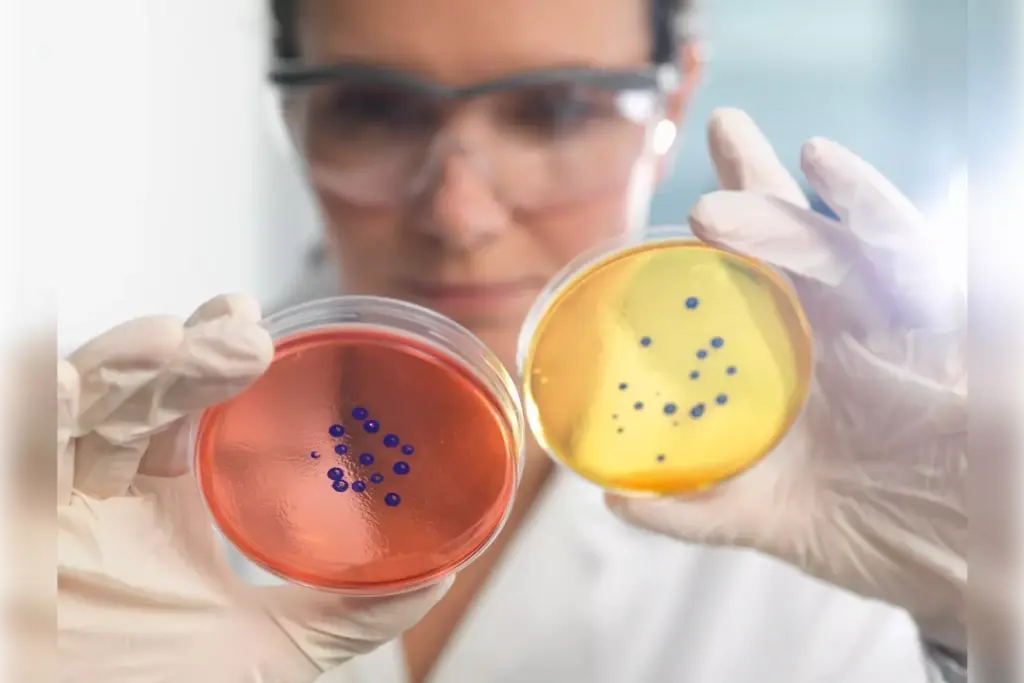
b lymphocytes function b lymphocytes function

Last Updated on November 26, 2025 by Bilal Hasdemir

Understanding B lymphocytes is key to unlocking the immune system’s power. At Liv Hospital, we focus on our patients and strive for the best medical results. This shows how important B cell research and treatment are.
B lymphocytes, or B cells, are vital for the adaptive immune system. They help fight off pathogens through humoral immunity. B cells can turn into plasma cells and memory cells, which make and keep antibodies.
B cells are very important for our health. If they don’t work right, it can cause many immune problems. Knowing how B cells work and grow helps us see their role in keeping us healthy.
Key Takeaways
- B lymphocytes are essential for humoral immunity.
- They produce antibodies to fight pathogens.
- B cells can differentiate into plasma cells and memory cells.
- Understanding B cell development is key for better immune system research.
- B cell problems can cause immune-related disorders.
The Fundamental Role of B Cells in Adaptive Immunity
B lymphocytes are key to our immune system. They help fight off many pathogens. They do this by making antibodies to neutralize or remove pathogens.
Definition and Basic Characteristics of B Lymphocytes
B lymphocytes, or B cells, are a type of white blood cell. They grow into cells that make antibodies. They are central to the adaptive immune system, recognizing and responding to specific antigens.
Their development starts in the bone marrow. Here, they go through many steps to become mature B cells.
B cells can recognize antigens through their surface-bound immunoglobulins. When they find their specific antigen, they get activated. They then multiply and turn into antibody-secreting plasma cells or memory B cells.
Historical Discovery and Naming of B Cells
Understanding B cells has grown over time. It wasn’t until the 1960s that we knew the difference between T cells and B cells. The name “B cell” comes from their development in the bursa of Fabricius in birds.
“The discovery of the bursa of Fabricius in birds and its role in the development of B cells was a landmark in immunology, leading to a deeper understanding of lymphocyte development and function.”
In humans and other mammals, B cells develop in the bone marrow. This shows a common process across species. Research has shed light on B cell development stages and factors influencing their maturation.
| Stage | Description | Location |
|---|---|---|
| Pro-B Cell | Early stage of B cell development | Bone Marrow |
| Pre-B Cell | Intermediate stage with initial immunoglobulin gene rearrangements | Bone Marrow |
| Mature B Cell | Fully developed B cell capable of recognizing antigens | Peripheral Lymphoid Organs |
Knowing where B lymphocytes are made and how they develop is key. It helps us understand their role in fighting off pathogens.
B Lymphocytes Function in Humoral Immune Response
When B lymphocytes are activated, they turn into plasma cells. These cells make antibodies, which are key to fighting infections. This is how we keep our immune system strong.
Antibody Production and Secretion
Activated B lymphocytes become plasma cells. These cells are made to produce lots of antibodies. Antibodies are proteins that find and stick to specific antigens, helping to get rid of them.
Creating antibodies involves several important steps. These include gene rearrangement, transcription, and translation. After they’re made, antibodies go into the blood and fluids. There, they can find and stick to pathogens.
Neutralization of Pathogens Through Antibodies
Antibodies are key in stopping pathogens by sticking to them. This stops them from attaching to and getting into host cells. This is a big step in stopping infections and diseases.
The table below shows how antibodies fight different pathogens.
| Pathogen Type | Antibody Mechanism | Outcome |
|---|---|---|
| Bacteria | Binding to bacterial surface proteins | Prevents adhesion to host cells |
| Viruses | Blocking viral attachment proteins | Inhibits viral entry into host cells |
| Toxins | Neutralizing toxin activity | Prevents toxin-mediated damage |
In summary, B lymphocytes are vital for the humoral immune response. They turn into plasma cells that make antibodies. These antibodies are essential in fighting off pathogens, keeping us safe from infections.
Types of B Lymphocytes and Their Specialized Roles
B cells come in many types, each playing a key role in fighting off infections. We’ll look at how different B cells help our immune system.
B-1 and B-2 Cell Subsets
B cells are split into B-1 and B-2 types. B-1 cells make natural antibodies to fight common germs right away. B-2 cells, on the other hand, are key for our body’s long-term defense.
B-1 cells include B-1a and B-1b, with B-1a making IgM antibodies. These are important for early defense. B-2 cells are vital for our body’s long-term defense, creating plasma cells and memory B cells.
Follicular B Cells and Germinal Center Reactions
Follicular B cells live in lymphoid organs’ follicles. They start germinal center reactions. This process makes B cells better at fighting off germs.
- Follicular B cells work with follicular helper T cells in germinal centers.
- In germinal centers, B cells multiply and change quickly.
- High-affinity B cells are chosen through affinity maturation.
Marginal Zone B Cells and Rapid Response
Marginal zone B cells are in the spleen’s marginal zone. They quickly respond to germs in the blood. They can fight off germs fast, often without T cells’ help.
“Marginal zone B cells play a critical role in the immediate response to pathogens, bridging the innate and adaptive immune responses.”
In summary, B cells like B-1, B-2, follicular, and marginal zone each have unique roles. Knowing about these B cell types helps us understand how our immune system works.
B Cell Activation and Antigen Recognition Mechanisms
B cells are vital for our immune system. They activate to fight off infections. This starts when they recognize antigens with their B cell receptors.
B Cell Receptors Structure and Function
B cell receptors (BCRs) are on B cells’ surfaces. They find and bind to specific antigens. The BCR is made of a membrane-bound immunoglobulin that grabs onto antigens.
When an antigen binds, it starts a chain of signals. This activates the B cell. BCRs also help internalize antigens for T cells to see. This is key for T cell activation.
T Cell-Dependent and T Cell-Independent Activation Pathways
B cell activation happens in two ways: with or without T cells.
- T Cell-Dependent Activation: T helper cells help here. B cells grab antigens and show them to T helper cells. This teamwork activates B cells to make antibodies or memory cells.
- T Cell-Independent Activation: No T cells needed here. Some antigens, like polysaccharides, can activate B cells directly. This makes IgM antibodies fast to fight off infections.
Knowing how B cells work is key to understanding our immune defense. It also helps us see why problems can lead to diseases.
How Activated B Lymphocytes Differentiate Into Effector Cells
Activated B lymphocytes can turn into plasma cells or memory B cells. This choice is key for a strong immune response.
Plasma Cell Development and Antibody Secretion
Plasma cells focus on making and releasing antibodies. When B lymphocytes get activated, they change into plasma cells. This change lets them make lots of antibodies.
“The development of plasma cells is a critical step in the humoral immune response, as it allows for the production of antibodies that can recognize and bind to specific pathogens,” highlighting the importance of this process in providing immunity against infections.
Memory B Cell Formation and Long-term Immunity
Memory B cells also come from activated B lymphocytes. They help fight off infections by remembering pathogens and responding fast.
Creating memory B cells involves many steps. These cells can live long and quickly react to infections again.
Key characteristics of memory B cells include:
- Long-term survival
- Rapid response to antigen re-exposure
- Ability to differentiate into plasma cells upon secondary antigen encounter
We see that plasma cells and memory B cells are vital for a good immune response. Learning how B lymphocytes become these cells helps us understand how we stay healthy.
The Developmental Journey of B Lymphocytes
B lymphocytes start from hematopoietic stem cells in the bone marrow. They go through many steps to become mature B cells. This journey is complex and essential for the immune system.
Hematopoietic Stem Cells to Pro-B Cells in Bone Marrow
The first step is when hematopoietic stem cells decide to become B cells. These stem cells are in the bone marrow. They start to change into B cell progenitors.
Pro-B cells then begin to change into B cells. They go through genetic changes, like rearranging immunoglobulin genes. This is key for making different antibodies.
For more on hematopoietic stem cells, check out Liv Hospital’s page.
Maturation Stages from Pre-B Cells to Naive B Cells
After pro-B cells, B cells mature into pre-B cells. They rearrange their genes again and start making pre-B cell receptors. This is important for their survival.
Eventually, they become naive B cells. These are mature B cells ready to fight off infections. They move to the spleen and lymph nodes to wait for their antigen.
- Key stages in B cell development:
- Hematopoietic stem cells
- Pro-B cells
- Pre-B cells
- Naive B cells
Knowing how B lymphocytes develop helps us understand the immune system better. It also sheds light on how diseases affect it.
Molecular and Cellular Mechanisms of B Cell Development
B cell development is a complex process. It involves molecular signals and cellular interactions. Key players include transcription factors, signaling pathways, and genetic rearrangements.
The journey of B cell development starts in the bone marrow. Here, hematopoietic stem cells turn into B cells through different stages. Key transcription factors are vital in this process.
Key Transcription Factors and Signaling Pathways
Transcription factors like E2A, EBF1, and PAX5 are essential. They control the genes needed for B cell development, survival, and growth.
- E2A: Important for early B cell development and immunoglobulin gene rearrangement.
- EBF1: Crucial for B cell lineage specification.
- PAX5: Essential for B cell commitment and maintaining B cell identity.
Signaling pathways, such as Notch and Wnt, also play a role. They help in making cell fate decisions and survival.
Immunoglobulin Gene Rearrangements
Immunoglobulin gene rearrangements are key in B cell development. They allow B cells to create a wide variety of antibodies.
| Stage | Rearrangement Event | Outcome |
|---|---|---|
| Pro-B cell | DH-JH joining | Start of heavy chain rearrangement |
| Pre-B cell | VH-DJH joining | Heavy chain rearrangement complete |
| Immature B cell | VL-JL joining | Light chain rearrangement and IgM expression |
“The rearrangement of immunoglobulin genes is a critical process. It allows B cells to produce a vast array of antibodies. This gives the immune system the ability to recognize and respond to many pathogens.”
Histology of B Lymphocytes Throughout Development
The development of B cells can be traced through histology. It shows changes from the bone marrow to peripheral lymphoid organs.
As B cells mature, they move to secondary lymphoid organs. There, they differentiate and are selected further. Understanding these histological changes gives insights into the complex B cell development process.
Advanced Functions of B Cells Beyond Antibody Production
B cells are more than just antibody makers. They play a big role in our immune system, including making cytokines and presenting antigens. Their work in the immune response is complex and vital.
Cytokine Production and Immunomodulatory Effects
B cells make cytokines that control the immune response. Cytokines like IL-10, IL-6, and TNF-α are key in shaping the immune environment. They help other immune cells by either starting inflammation or stopping it, depending on the situation.
For example, regulatory B cells (Bregs) make IL-10. This helps keep inflammation in check and keeps the immune system balanced. This effect is vital in stopping autoimmune diseases and making sure the immune response is right.
Antigen Presentation and T Cell Interactions
B cells are also good at presenting antigens to T cells. They help start and guide the adaptive immune response. This function is key for fighting off infections and diseases.
B cells and T cells talk to each other. B cells present antigens to T cells, and T cells send signals back to B cells. This communication is important for a strong immune response and for making memory B cells and plasma cells.
Learning about B cells’ advanced roles shows how important they are in keeping us healthy. They could also be a focus for new treatments for immune problems.
B Lymphocyte Disorders and Clinical Applications
B lymphocytes are key to our immune system. When they don’t work right, we get different disorders. Knowing about these helps us find better treatments and improve care for patients.
Primary and Secondary B Cell Immunodeficiencies
B cell immunodeficiencies make it hard for our bodies to make antibodies. Primary immunodeficiencies are genetic and start at birth. Secondary immunodeficiencies come from infections, medicines, or getting older.
Primary B cell immunodeficiencies include X-linked agammaglobulinemia and common variable immunodeficiency. These lead to frequent infections and need careful treatment, like immunoglobulin therapy.
Secondary B cell immunodeficiencies can happen from HIV, some cancers, or medicines that weaken the immune system. We treat these by fixing the cause and helping the immune system.
B Cell Malignancies and Lymphomas
B cell malignancies, like lymphomas and leukemias, start from B lymphocytes. They can be very different in how aggressive they are and how they’re treated.
Types of B cell lymphomas include diffuse large B cell lymphoma and follicular lymphoma. We use chemotherapy, radiation, targeted therapies, and immunotherapy to treat them.
Thanks to better diagnostics and treatments, patients with B cell malignancies are doing better. Personalized medicine is key in managing these complex diseases.
Innovative Approaches in B Cell Therapy at Liv Hospital
Liv Hospital is leading in B cell therapy. Our team works hard to give the latest treatments for B cell disorders.
Monoclonal antibodies and CAR-T cell therapy are promising in B cell therapy. They offer hope for patients with hard-to-treat B cell cancers.
We’re also looking into gene editing technologies for B cell immunodeficiencies. Our team makes sure patients get care that fits their needs.
Conclusion: The Critical Importance of B Lymphocytes in Immune Health
B lymphocytes are key to our immune system. When they don’t work right, we can get sick. It’s important to know how they work to find better treatments.
We’ve seen how B cells help our body fight off infections. They grow and change to make antibodies. This is how they keep us safe from diseases.
Studies are finding out more about what B cells do. They make antibodies and also help control the immune system. This helps us understand and treat immune diseases better.
Places like Liv Hospital are working on new B cell treatments. By learning more about B lymphocytes, we can make treatments better. This will help people get better faster and stay healthy.
What is the primary function of B lymphocytes in the immune system?
B lymphocytes are key in fighting off infections. They make antibodies to neutralize pathogens.
Where are B lymphocytes produced?
B lymphocytes start in the bone marrow. They come from hematopoietic stem cells.
What is the role of B cell receptors in B cell activation?
B cell receptors find and bind to antigens. This triggers B cell activation and starts an immune response.
How do activated B lymphocytes differentiate into effector cells?
Once activated, B lymphocytes turn into plasma cells and memory B cells. Plasma cells make antibodies, and memory B cells help fight off future infections.
What are the different types of B lymphocytes and their specialized roles?
There are many types of B lymphocytes. B-1 and B-2 cells, follicular B cells, and marginal zone B cells all play unique roles in the immune system.
How do B cells interact with T cells?
B cells show antigens to T cells. This helps activate T cells and shapes the immune response through cytokine production.
What are the consequences of B lymphocyte disorders?
Disorders in B lymphocytes can cause weak immune systems, cancer, and autoimmune diseases. This shows how vital B cells are for our health.
What is the significance of B cell therapy in treating immune-related diseases?
B cell therapy, like what’s done at Liv Hospital, is a new way to treat B cell-related diseases. It helps with immunodeficiencies and cancers.
How do B cells contribute to long-term immunity?
B cells help us fight off infections again by creating memory B cells. These cells allow for quick responses to future infections.
What are the key transcription factors and signaling pathways involved in B cell development?
Certain transcription factors and signaling pathways guide B cell development. This includes immunoglobulin gene rearrangements and histological changes.
References
- Althwaiqeb SA. Histology, B-Cell Lymphocyte (StatPearls, NBK560905). Available from: https://www.ncbi.nlm.nih.gov/books/NBK560905/
- British Society for Immunology / Immunology.org. B cells (B-lymphocytes). Available from: https://www.immunology.org/public-information/bitesized-immunology/cells/b-cells
- NCBI Bookshelf. Introduction to T and B lymphocytes (NBK459471). Available from: https://www.ncbi.nlm.nih.gov/books/NBK459471/
- LeBien TW, Tedder TF. B-lymphocytes: how they develop and function. Blood. 2008;112(5):1570-1580. Available from: https://ashpublications.org/blood/article/112/5/1570/25424/B-lymphocytes-how-they-develop-and-function
- Akadeum Life Sciences. B cell / B-Cell Technology & Overview. Available from: https://www.akadeum.com/b-cell/